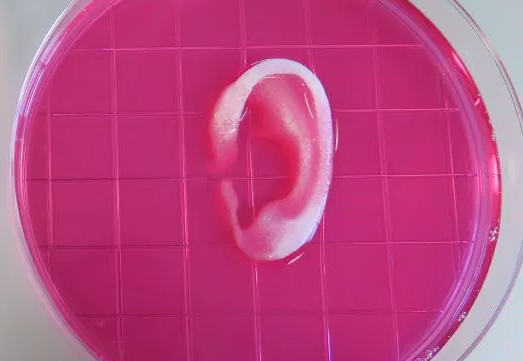
Screen Shot 2016-02-15 at 8.59.46 PM

3D print lichaam
Weer een stapje verder: deze 3D-printer gebruikt ‘hydrogels’ – een oplossing van water met menselijke cellen – om ‘onderdelen’ te produceren. Een oor, een stuk kaakbeen. Als het materiaal is opgedroogd zou het kunnen worden aangebracht. Maar zo ver is het nog niet.
No country for old men

Opperrechter Antonin Scalia – een nare man – overleed op Cibolo Creek Ranch in West Texas, een van de dunst bevolkte gebieden van de Verenigde Staten. 2400 vierkante mijl, 2400 inwoners. Twee rechters waren op honderden kilometers afstand en konden niet komen om de dood vast te stellen; nummer drie in de volgorde deed het tenslotte per telefoon met hulp van een federale marshall ter plekke. De ranch werd in 1857 gesticht door pionier en cowboy Milton Faver. Scalia was toeschouwer bij een kwarteljacht.
The Big Short 2
Sommige beleggingsfondsen wedden nu dat China zijn yuan zal moeten devalueren. Waarom? Omdat de leningen van de banken samen te groot zijn (340% van BNP), vol rotte appels, en vroeg of laat zullen leiden tot deconfitures die het systeem onderuit halen – net als in 2008 de te zwaar beleende hypotheekmarkt in de VS leidde tot de financiele crisis – en het meesterlijke boek van Michael Lewis.
Sci-Hub
Piratensite voor wetenschappelijk onderzoek. Omzeilt betaalmuren van wetenschappelijke uitgevers zoals Elsevier en maakt vrijwel alle wetenschappelijk onderzoek gratis beschikbaar. Nu 48 miljoen ‘papers’ ontsloten. Krijgt toegangscodes van bevriende wetenschappers. Heel slim: als je op een betaalmuur stuit hoef je tegenwoordig alleen nog maar de URL van sci-hub in de URL van het artikel te plakken, achter de naam van het tijdschrift (dus achter .com of .org) en voor de code van het artikel. Uitgevers zeggen ‘dit is diefstal’ en procederen; de Kazakhstaanse studente neurowetenschappen en oprichter van Sci-Hub verweert zich met argument dat wetenschappers elkaar al jaren passwords cadeau doen, maar dan per post, op een forum of per twitter. Amerikaanse rechter gaf Elsevier gelijk in oktober; sci-hub gaf zichzelf een ander adres, nu sci-hub.io.
Update 2 mei 2016: URL is nu sci-hub.cc (tip van Gijs Broersen)
Al ons water

… in alle oceanen, rivieren, ijsbergen, gletsjers en meren van de wereld plus al het water dat in levende wezens zit – past in die grotere ballon; in die kleinere zit al het zoetwater. Prof. Hoekstra van U Twente zegt dat vier miljard mensen regelmatig watertekort hebben.
Wat verdient leraar?

‘Lower secondary school,’ zullen we zeggen brugklasleraar? Trek uw eigen conclusies uit het staatje. Mijne: grote verschillen tussen hoog-laag. Mexico bijna 1:4 tussen laagste en hoogste; in Finland, dat wordt geroemd om zijn onderwijs, geen ‘promotie’ mogelijk want verschil tussen laagste en hoogste is maar 35%. Duidelijk dat salarissen in ‘dure’ landen hoger liggen maar Engeland, Schotland en Japan zitten tussen de ‘armere’ landen.

Ershad is de naam van de ‘moraliteitspolitie’ in Iran en Gershad is de naam van een app die gebruikers vertelt waar ze staan te controleren. Een soort Flitsmeister voor vrouwen die makeup willen dragen.
Recht om vergeten te worden
Google kreeg opdracht van Europese Hof om ‘right to be forgotten’ op te nemen: als je vindt dat je onterecht op het net staat, en de rechter is het met je eens, kan die Google bevelen bepaalde nieuwsitems te verwijderen. Google beperkte dat tot artikelen met een lokale url (dus .nl bijvoorbeeld) maar zo kon je laster niet aanpakken als die stond op .com. Nu wil Google de methode veranderen, zegt TechCrunch: niet de plek van het artikel maar de fysieke standplaats van de zoeker zal bepalen welke artikelen worden afgegrendeld.

